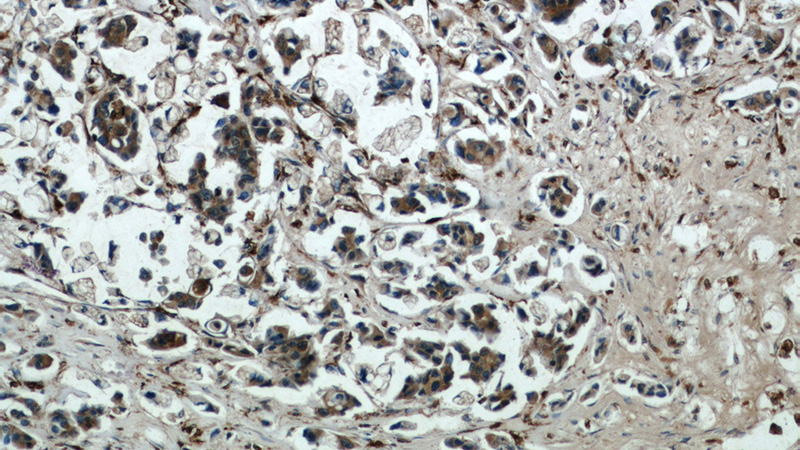
Immunohistochemical of paraffin-embedded human breast cancer using Catalog No:108887(CTSB antibody) at dilution of 1:50 (under 10x lens)

-
Product Name
Cathepsin B antibody
- Documents
-
Description
Cathepsin B Rabbit Polyclonal antibody. Positive FC detected in MCF-7 cells. Positive IHC detected in human breast cancer tissue, human colon cancer tissue, human ovary tumor tissue. Positive IF detected in A375 cells. Positive WB detected in A375 cells, HT-1080 cells, human brain tissue, human liver tissue, mouse brain tissue, NIH/3T3 cells, RAW264.7 cells. Observed molecular weight by Western-blot: 38 kDa, 44 kDa
-
Tested applications
ELISA, WB, IHC, IF, FC
-
Species reactivity
Human, Mouse; other species not tested.
-
Alternative names
APP secretase antibody; APPS antibody; cathepsin B antibody; Cathepsin B1 antibody; CPSB antibody; CTSB antibody
-
Isotype
Rabbit IgG
-
Preparation
This antibody was obtained by immunization of Cathepsin B recombinant protein (Accession Number: XM_011543812). Purification method: Antigen affinity purified.
-
Clonality
Polyclonal
-
Formulation
PBS with 0.1% sodium azide and 50% glycerol pH 7.3.
-
Storage instructions
Store at -20℃. DO NOT ALIQUOT
-
Applications
Recommended Dilution:
WB: 1:200-1:2000
IHC: 1:20-1:200
IF: 1:10-1:100
-
Validations

A375 cells were subjected to SDS PAGE followed by western blot with Catalog No:108887(CTSB antibody) at dilution of 1:800
Immunohistochemical of paraffin-embedded human breast cancer using Catalog No:108887(CTSB antibody) at dilution of 1:50 (under 10x lens)

Immunohistochemical of paraffin-embedded human breast cancer using Catalog No:108887(CTSB antibody) at dilution of 1:50 (under 40x lens)

Immunofluorescent analysis of A375 cells using Catalog No:108887(Cathepsin B Antibody) at dilution of 1:25 and Alexa Fluor 488-congugated AffiniPure Goat Anti-Rabbit IgG(H+L)

1X10^6 MCF-7 cells were stained with 0.2ug Cathepsin B antibody (Catalog No:108887, red) and control antibody (blue). Fixed with 90% MeOH blocked with 3% BSA (30 min). Alexa Fluor 488-congugated AffiniPure Goat Anti-Rabbit IgG(H+L) with dilution 1:1500.
-
Background
CTSB(Cathepsin B) is also named as CPSB and belongs to the peptidase C1 family. It participates in intracellular degradation and turnover of proteins. Cathepsin B precursors found in human malignant ascites fluid do not possess mannose-rich carbohydrates suggesting that a defect in the post translational processing of carbohydrate moieties on tumor. Cathepsin B exists as both glycosylated and unglycosylated forms(PMID:1637335). In rat macrophages and hepatocytes pro- cathepsin B is 39 kDa (unglycosylated =35 kDa), whereas in human fibroblasts procathepsin B is 44.5-46kDa (unglycosylated=39kDa)(PMID:2097084). It can be detected the 43 kDa form of pro-CTSB, 31 kDa and 25 kDa marure forms in mouse brain by western blot(PMID:20616152).
-
References
- Xiang Y, Yan C, Guo X. Host-derived, pore-forming toxin-like protein and trefoil factor complex protects the host against microbial infection. Proceedings of the National Academy of Sciences of the United States of America. 111(18):6702-7. 2014.
- Yan Y, Zhou K, Wang L, Zhou Y, Chen X, Fan Q. Expression of cystatin C and its effect on EC9706 cells in esophageal carcinoma. International journal of clinical and experimental pathology. 8(9):10102-11. 2015.
Related Products / Services
Please note: All products are "FOR RESEARCH USE ONLY AND ARE NOT INTENDED FOR DIAGNOSTIC OR THERAPEUTIC USE"
